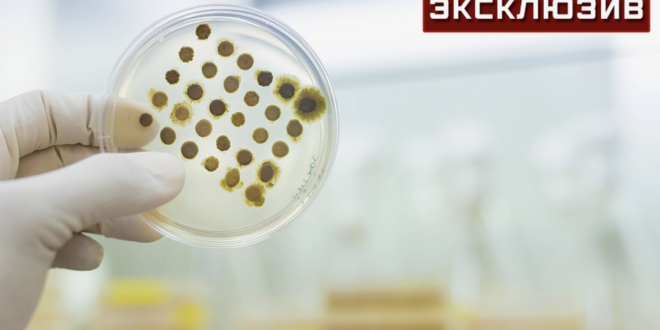

В России из-за активно распространяющейся менингококковой инфекции нужно принимать срочные меры. Зафиксировано уже 1,2 тысячи случаев заражения.
При этом за весь 2024 год было диагностировано 600 случаев инфицирования. Врач-инфекционист, кандидат медицинских наук Екатерина Степанова указала, что данная тенденция говорит о необходимости введения дополнительных мер, в частности вакцинации.
Со Степановой согласился ее коллега Михаил Фаворов, который также призвал внести вакцинацию от указанной инфекции в календарь прививок. Ее лучше проводить определенными вакцинами, которые будут давать иммунитет на все серотипы. Такие средства уже изобретены, подчеркнул специалист.
«Эти вакцины есть, они изобретены, надо вложить деньги в их производство и начать выпускать», — заявил
Прививка от менингококка входит в календарь вакцинации по эпидемиологическим показаниям. При этом всеобщей иммунизации населения нет, что на самом деле необходимо, указал Фаворов.
![]()
Рост случаев менингококковой инфекции педиатр Лилит Аракелян объяснила несколькими факторами. Так, некоторые родители из-за пандемии COVID-19 пропустили или отложили прививки. Кроме того, стало расти количество завозных случаев инфекции после активизации поездок за рубеж, а также число противников вакцинации.
«Что делать? Прививка — единственный способ профилактики. В России зарегистрированы и доступны вакцины от менингококков группы A, C, W, Y, а также B», — заключила специалистка.
Врач-инфекционист Андрей Матюхин отмечал, что опасная инфекция распространяется в России в том числе из-за мигрантов.
По словам специалиста, вызывающая заболевание бактерия может распространяться из-за приезжих из стран Африки и Азии. При этом он добавил, что способствовать распространению болезни могут общее снижение иммунитета и замедление темпов ревакцинации.
Менингококковая инфекция — острое инфекционное заболевание, вызываемое менингококком. Она может приводить к тяжелым поражениям головного мозга и всего организма.
Русские новости Будь в курсе страны